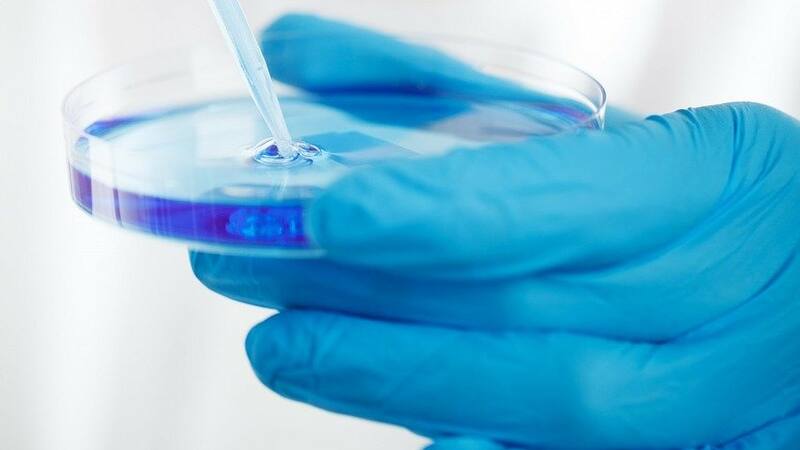

Por Carlos MontesLa otra desigualdad en Chile: El 65% de la producción científica se hace en Santiago muy lejos de Valparaíso y Biobío, que suman el 13% cada una
Este jueves, en la antigua sede del Congreso Nacional, Guido Girardi, presidente de la Comisión Desafíos del Futuro, y Flavio Salazar, futuro ministro de Ciencia, presentaron el libro “Chile tiene su futuro desde sus territorios”, el que detalla, entre otras temáticas, las grandes diferencias en inversión científica que aún existen entre regiones y la capital.
“Si uno fuera religioso, diría que Chile está bendecido, en el sentido que los territorios de Chile van a jugar un rol fundamental para enfrentar los desafíos que tiene la humanidad en el siglo XXI”.
Así de enfático es Guido Girardi, senador y presidente de la Comisión Desafíos del Futuro, Ciencia, Tecnología e Innovación del Senado, instancia que suma más de una década y que este jueves presentó un documento de 546 páginas llamado “Chile tiene su futuro desde sus territorios”, un resumen del trabajo de la comisión correspondiente al período 2018-2022, el que fue entregado al nuevo Gobierno.
En una primera edición, publicada en Qué Pasa, se revelaron los mayores logros conseguidos por la comisión. En este capítulo, el documento aborda uno de los principales desafíos científicos a nivel nacional, la regionalización y centralización.
El documento establece, en relación a la producción científica nacional entre 2008 y 2019, que existe una enorme desigualdad entre el financiamiento para investigación que se destina a la Región Metropolitana y el resto del país. La geografía de Chile es una invitación perfecta para pensar la distribución de la investigación de acuerdo con necesidades específicas de los territorios. Sin embargo, Chile se piensa desde Santiago y se destinan pocos recursos para las zonas que necesitan con mayor urgencia que se piensen sus modelos productivos y ambientales, establecen los autores del informe.
En uno de estos capítulos, titulado “Vocación territorial de las universidades vs. centralismo investigativo - Desigualdades de la investigación científica de las universidades en Chile”, se analiza en detalle esta desigualdad.
Girardi explica que el país necesitainstituciones que sean capaces de generar ese proceso de cambio, adaptación y reflexión, además producto de la era digital, una de las características que estamos viviendo es la de la presión por la inmediatez. “No hay pensamientos estratégicos. El Congreso y Comisión Futuro intentaron generar un modelo de trabajo que estuviera en la frontera de los cambios, que fuera contemporáneo a los cambios que se producen en el mundo. Cuando haces una ley que dura 15 años, puede que cuando la terminen esté obsoleta porque ya cambió el mundo”.
Marek Hoehm, politólogo, investigador y asesor parlamentario en la Sección Estudios de la Biblioteca del Congreso Nacional, y uno de los autores de este capítulo, señala aque este acápite, al igual que el informe, refleja una primera fase del trabajo de la Comisión Desafíos del Futuro, “en la que se ha logrado establecer un método de trabajo colectivo (mesas de trabajo) y se ha logrado orientar la formulación de políticas públicas sobre una base científica”.
Dice que al mismo tiempo se ha logrado fortalecer la integración de los rectores del Consejo de Rectores de las Universidades Chilenas (Cruch) y otros destacados miembros de la comunidad científica en la labor de esta comisión legislativa del Senado. “Lo anterior constituye una particularidad importante, ya que estos miembros de la comunidad científica están facultados para presentar proyectos de ley en esta comisión”, añade.
El siguiente gráfico deja en claro las diferencias entre la Región Metropolitana y las demás regiones del país. Se aprecia que el 64,84% de la producción científica en Chile se da en la Región Metropolitana, repartiéndose el 53,7% restante entre todas las universidades del país. Valparaíso y Biobío se “acercan” con apenas un 13%.

Hoehm explica que se logró avanzar en esta colaboración creando un Consejo Asesor del Congreso del Futuro, “que integran los representantes de las universidades chilenas y también se avanzó hacia la formulación de Estrategias Nacionales para el Desarrollo, por ejemplo, de la inteligencia artificial o del hidrógeno verde para llegar, en una tercera fase, a formular y aprobar proyectos de ley con base científica como la muy connotada iniciativa de neuroderechos”.
Con respecto a la inversión en regiones, el senador explica que cuando un país destina el 0,34% del PIB a la ciencia, “está destinado al fracaso, está destinado a morir. Y Chile tiene una ventana de oportunidades. En el caso de litio y el cobre, la ventana de la electromovilidad será a 20 años, si no lo desarrolla en esa fecha, ya no lo podrá usar, porque va a ser sustituido por iones de sodio. Si no aprovecha la oportunidad, lo va a hacer otro”.
Dice que se debe tener una institucionalidad que sea armónica y en sincronía con la velocidad de los sucesos que están ocurriendo, y la Comisión del Futuro es un laboratorio de innovación social, que en el fondo es un espacio de encuentro e intersección, el capital intelectual y científico más importante de Chile, donde están todas sus universidades, la Academia de Ciencia y los científicos más importantes del mundo. “Nosotros estamos vinculados con los principales científicos del planeta, que unen al mundo político y científico, y con el mundo empresarial, el territorio y la unidad civil”, añade Girardi.
Ciencias Exactas y Naturales lideran las preferencias
La Convención Constitucional será fundamental, considera Girardi. “Para que el país por lo menos llegue a tener unos 2 puntos del PIB dedicado a ciencia. Estos desarrollos permitirán que Chile logre una igualdad, porque Chile hoy tiene un modelo exportador de recursos naturales, y la renta del capital natural se queda en muy pocas manos, además con un gigantesco impacto ecológico. Y no le llega al conjunto de los ciudadanos”.
El senador agrega que esta estrategia de desarrollo “que estamos planteando, requiere de valor agregado, de participación de químicos, técnicos, se redistribuye la riqueza de manera importante, y hay más riqueza. Explotar litio a granel es un negocio de 2 mil millones de dólares, y si exportas baterías es un negocio 100 veces mayor al que tenemos con el litio a granel. Genera otros encadenamientos productivos”.
Hoehm considera, que en definitiva, “el libro presentado da cuenta de la labor realizada en la Comisión Desafíos del Futuro, de su propuesta metodológica inicial, de sus avances en tres etapas y de sus resultados principales. Cada una de las mesas de trabajo dispone de material y reflexiones que van mucho más allá de los textos resumidos publicados en el libro, por lo que es probable que existan otras publicaciones de su trabajo”.
Habría mayor igualdad, mayor protección ambiental, mayor crecimiento. “El crecimiento económico está en los territorios, está en el desarrollo, pero armónico, en conjunto con éstos, el mundo científico y privado. La gracia de lo que ha hecho la Comisión del Futuro es generar un modelo”, señala el presidente de la comisión.
Financiamiento desigual
En la siguiente tabla se evidencia la desigualdad de financiamiento por áreas de investigación y la realidad de cada región. La falta de planificación hace que espontáneamente los recursos tiendan a asignarse a ciertas áreas que tienen que ver con el desarrollo local, sin embargo, de modo general, en cada región se reproduce una desigualdad disciplinaria, siguiendo la tendencia de Santiago, explica el documento.
Resulta interesante, en este sentido, establece el informe, que en Aysén y en Atacama se destine el 80% y el 71,7% de la investigación a Ciencias Exactas y Naturales. Habría que ver cuánto de esto se relaciona con necesidades específicas del territorio y cuánto con cómo las autoridades desde Santiago imaginan las necesidades territoriales, agregan los responsables.

El senador establece que el documento analizado en este artículo, “no lo hicimos con los científicos chilenos solamente, trabajamos con los neurocientíficos más importantes del planeta, con Rafael Yuste, por ejemplo, que es el director mundial del proyecto Brain designado por Barack Obama. Participaron nuestros rectores de universidades directamente”.
Es una cosa paradojica, “Chile lo tiene todo, lo único que le falta es la inteligencia de sus habitantes. Los desafíos que tiene la humanidad son tres: enfrentar el cambio climático, desarrollar un chasis para la inteligencia artificial, sin ésta no va a sobrevivir la humanidad, y en tercer lugar, colonizar el espacio, el universo”, finaliza Girardi.
Siga leyendo en Qué Pasa:
COMENTARIOS
Para comentar este artículo debes ser suscriptor.
Lo Último
Lo más leído
Plan digital + LT Beneficios por 3 meses
Cobertura completa, análisis y beneficios para todo el año 🔍🎁$3.990/mes SUSCRÍBETE













